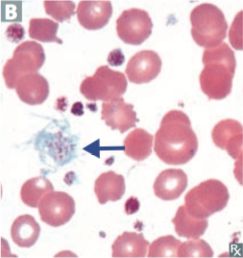
Flashcard 9 image

Which of the following is a discrete tumor mass arising from lymph nodes? _____

What form of non-Hodgkin lymphoma is seen in the image below? _____

What type of cell is represented in the image below? _____

The given peripheral smear shows abnormal _____ cells with fine hair-like cytoplasmic projections characteristic of hairy cell leukemia.

Tumor cells with multilobulated nuclei (“cloverleaf” or “flower” cells) is characteristic of _____

Patients with the O blood type cannot receive which blood types? _____
What unique antibodies in plasma do patients with the B blood type have? _____
Hint: name and isotype

Tumor cells with multilobulated nuclei (“cloverleaf” or “flower” cells) which is characteristic of _____ Leukemia/Lymphoma.

Blood smear of essential _____ shows markedly increased number of platelets, which may be large or abnormally formed
What unique antibodies in plasma do patients with the Rh- blood type have? _____
Anemias: Classification and Approach
Flashcards
Hemolytic Anemias
Flashcards
Myeloproliferative Neoplasms
Flashcards
Myelodysplastic Syndromes
Flashcards
Acute Leukemias
Flashcards
Chronic Leukemias
Flashcards
Lymphomas and Lymphoid Neoplasms
Flashcards
Plasma Cell Disorders
Flashcards
Bleeding Disorders
Flashcards
Thrombotic Disorders
Flashcards
Get full access to all flashcards, spaced repetition, and progress tracking.
Start For Free